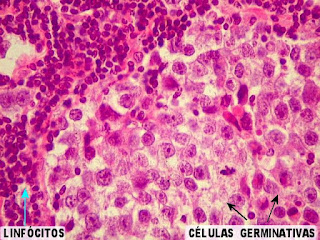

Mitose
A Mitose é um dos processo de divisão celular, onde a célula mãe origina duas células-filhas geneticamente idênticas, diploides e com cromossomos não duplicados. Esse tipo de divisão ocorre nas células somáticas e nas células germinativas que originarão novas células germinativas (olhar células somáticas e germinativas nas postagens anteriores).
A fase M é a divisão da célula propriamente dita, na mitose essa fase é composta de: prófase, metáfase, anáfase, telófase e citocinese.
** Prófase = inicia a divisão celular, ocorre a condensação dos cromossomos e a formação do fuso mitótico.
** Metáfase = fase intermediária, ocorre o desaparecimento da carioteca e a disposição dos cromossomos no centro da célula.
** Anáfase = quando os cromossomos migram para pólos opostos.
** Telófase = caracteriza-se pela descondensação dos cromossomos, reorganização da carioteca, o fuso mitótico desaparece.
** Citocinese = divisão do citoplasma que ocorre posteriormente à divisão nuclear (cariocinese) e completa o processo de divisão celular
** Citocinese = divisão do citoplasma que ocorre posteriormente à divisão nuclear (cariocinese) e completa o processo de divisão celular
Temos aqui o demonstrativo da mitose:
A Meiose também é um processo de divisão celular, ocorre em duas etapas, a meiose I e a meiose II. Na meiose I origina-se duas células haploides com cromossomos duplicados, e na meiose II origina-se duas quatro células-filhas haploides, com cromossomos não duplicados e diferentes da célula-mãe.
A meiose ocorre com células germinativas que dão origem aos gametas masculinos e femininos, ou aos esporos vegetais. A importância de ocorrer a meiose com os gametas, é que eles permanecem com metade do material genético, pois durante a fecundação, os gametas irão se unir e formar o zigoto, que é a primeira célula diploide do organismo.
A meiose ocorre com células germinativas que dão origem aos gametas masculinos e femininos, ou aos esporos vegetais. A importância de ocorrer a meiose com os gametas, é que eles permanecem com metade do material genético, pois durante a fecundação, os gametas irão se unir e formar o zigoto, que é a primeira célula diploide do organismo.
A seguir iremos descrever as fases da meiose:
** Prófase I = ocorre a condensação, organização e formam-se os pares de cromossomos homólogos.
** Metáfase I = cromossomos homólogos migram para o centro da célula.
** Anáfase I = os cromossomos homólogos migram para os pólos.
** Telófase I = duas células filhas são formadas por novos núcleos haploides.
Na meiose II ocorre da seguinte maneira:
** Prófase II = os cromossomos condensam,
** Metáfase II= os cromossomos se agrupam no centro da célula.
** Anáfase II = ocorre a separação das cromátides de cada cromossomo.
** Telófase II = nessa etapa, cada célula filha originada da meiose I, forma duas células, resultando em quatro células filhas.
** Metáfase I = cromossomos homólogos migram para o centro da célula.
** Anáfase I = os cromossomos homólogos migram para os pólos.
** Telófase I = duas células filhas são formadas por novos núcleos haploides.
Na meiose II ocorre da seguinte maneira:
** Prófase II = os cromossomos condensam,
** Metáfase II= os cromossomos se agrupam no centro da célula.
** Anáfase II = ocorre a separação das cromátides de cada cromossomo.
** Telófase II = nessa etapa, cada célula filha originada da meiose I, forma duas células, resultando em quatro células filhas.
Imagem simplificada das fases da meiose: